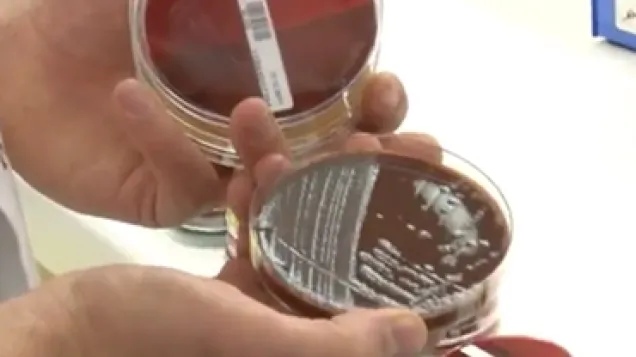
Video

ECDC country visit to Malta to discuss antimicrobial resistance issues, 3-7 July 2017
Risk assessment
The European Centre for Disease Prevention and Control (ECDC) and the European Commission's Directorate-General for Health and Food Safety, at the invitation of the Maltese authorities, jointly carried out a country visit from 3 to 7 July 2017. The overall aim of the visit was to assist them in the further development and implementation of their national policies and strategies for tackling antimicrobial resistance (AMR) based on a One Health perspective.
Publication file
ECDC country visit to Malta to discuss antimicrobial resistance issues, 3-7 July 2017
English (756.97 KB - PDF)Related files
Joint executive summary in respect of a one health country visit to Malta from 3 to 7 July 2017 to discuss policies relating to antimicrobial resistance
English (438.66 KB - PDF)More about country preparedness
See all updates on antimicrobial resistance
Share this page